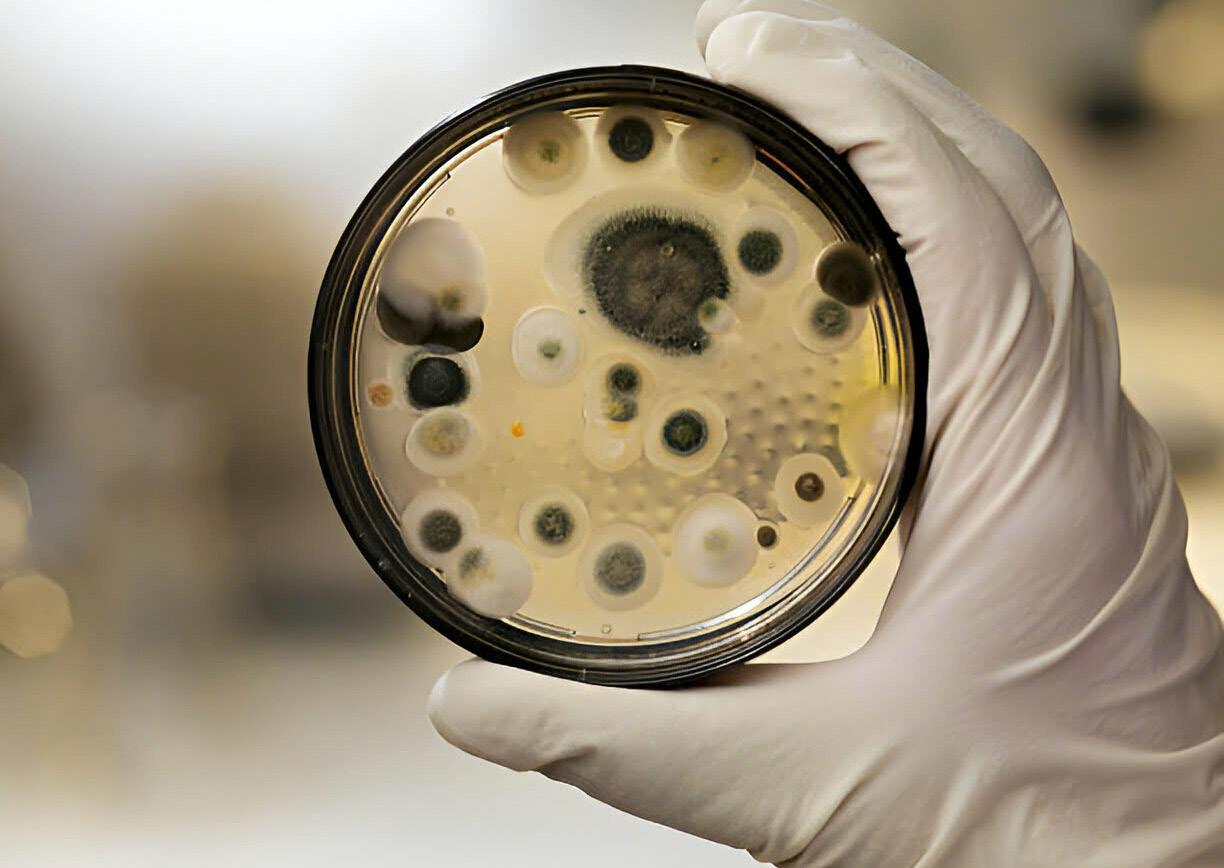
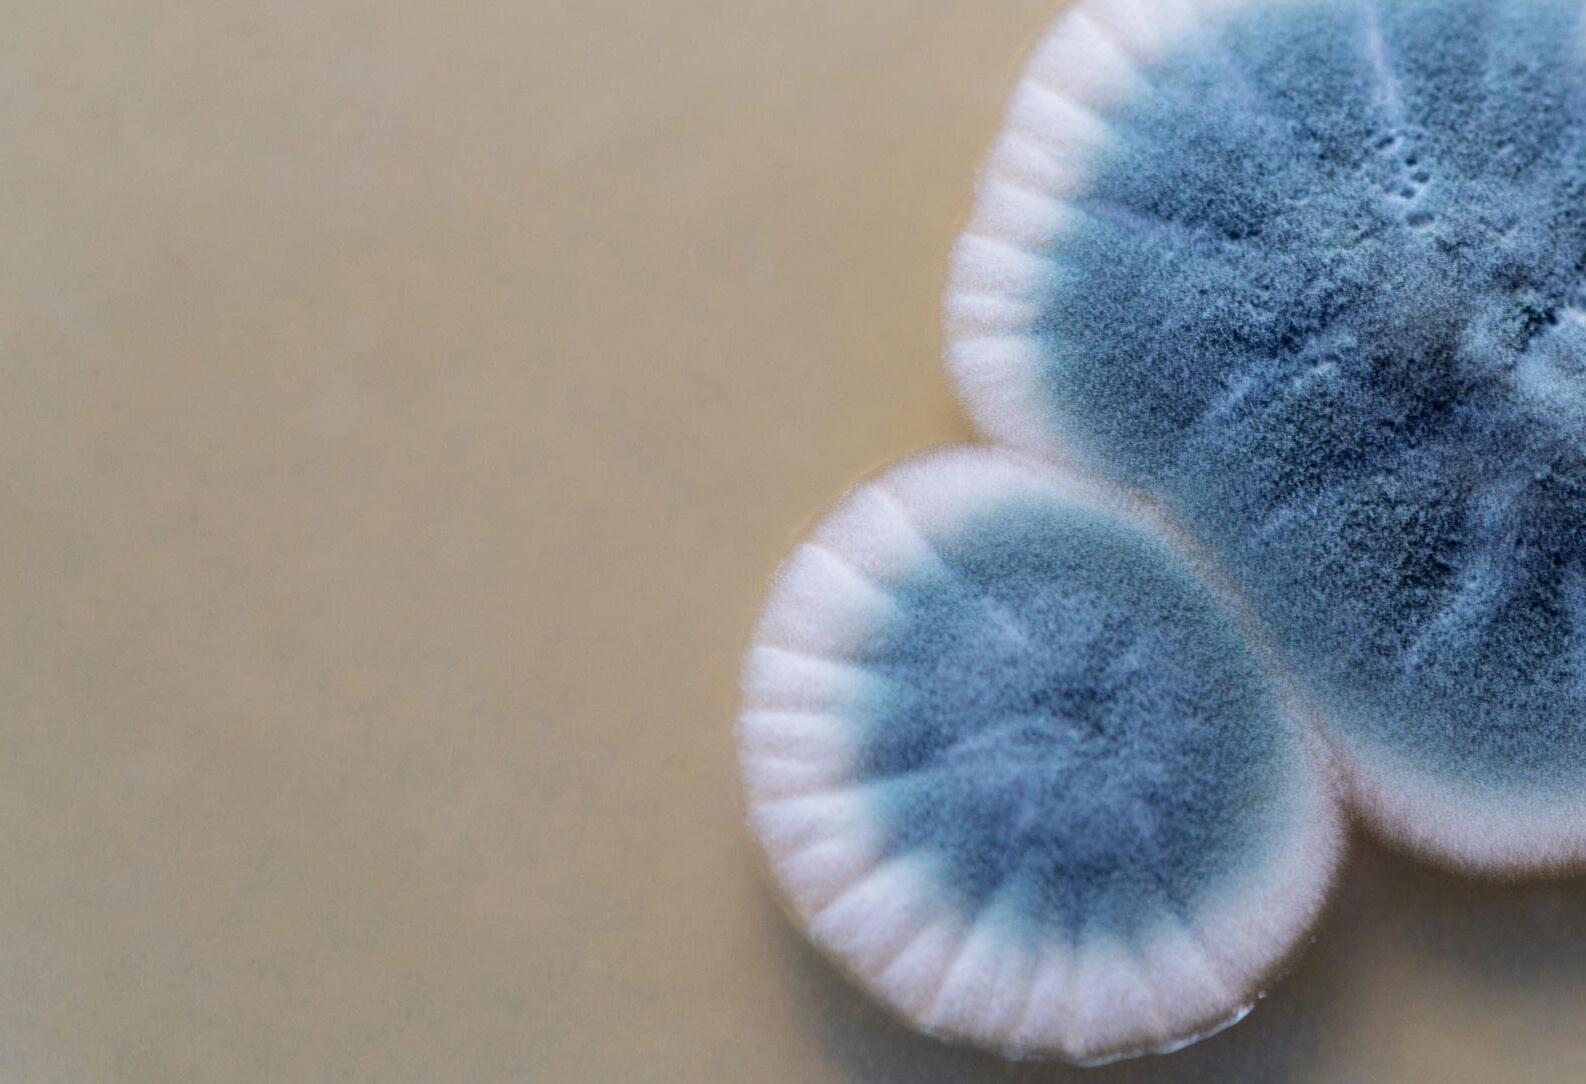
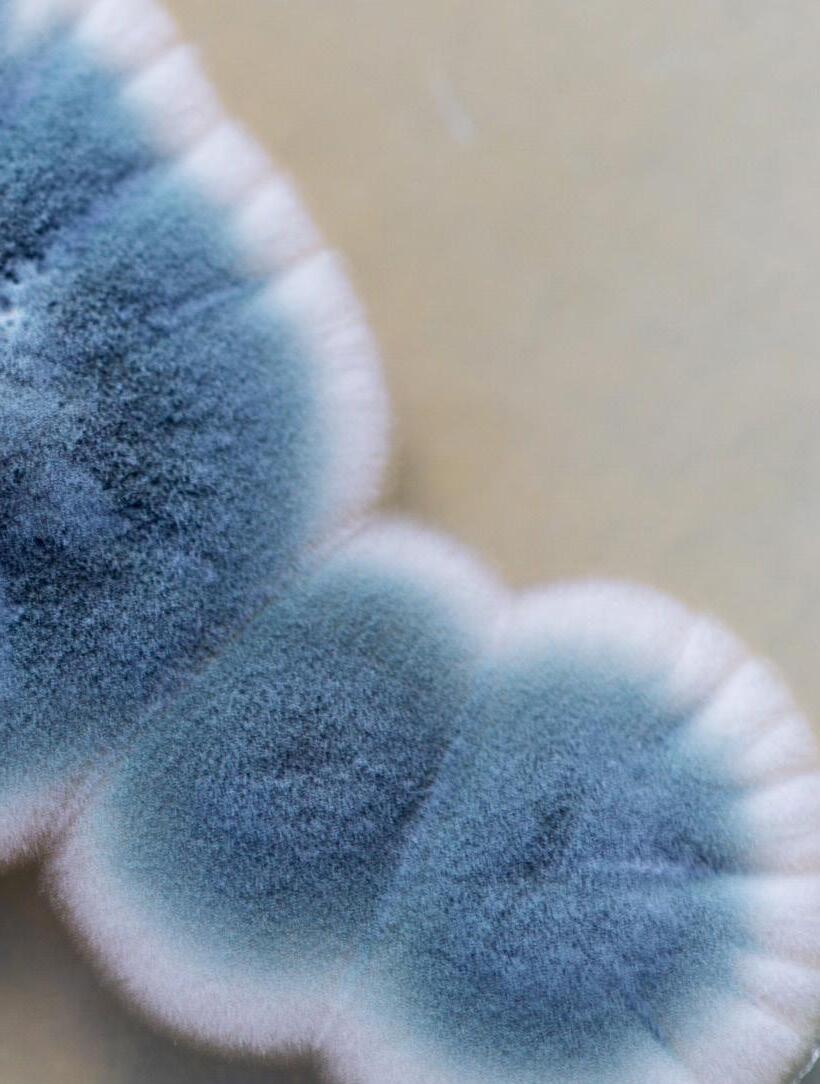

![]()



Kẻ thù thầm lặng




Quý độc giả thân mến, Nấm mốc – nghe qua tưởng chừng chỉ là những vệt loang lổ trên tường hay vài đốm đen xấu xí trên đồ dùng, nhưng thực tế, đây lại là một “kẻ thù thầm lặng” có thể ảnh hưởng nghiêm trọng đến sức khỏe, tài sản và chất lượng cuộc sống của mỗi gia đình. Trong điều kiện khí hậu nóng ẩm, câu chuyện chống ẩm, ngăn mốc không chỉ là vấn đề vệ sinh, mà còn là hành trình bảo vệ tổ ấm và duy trì một môi trường sống an toàn, trong lành.
Trong số tạp chí này, chúng tôi gửi đến Quý độc giả những kiến thức và giải pháp toàn diện: từ việc hiểu đúng về nấm mốc, nguyên nhân và dấu hiệu nhận biết sớm, cho đến các phương pháp phòng ngừa – xử lý hiệu quả – kiểm soát độ ẩm lâu dài. Đi kèm theo đó là các checklist thực hành hàng ngày.
Hy vọng rằng, những nội dung được chia sẻ trong số này sẽ trở thành người bạn đồng hành tin cậy, giúp Quý độc giả không chỉ bảo vệ ngôi nhà khỏi nấm mốc, mà còn nuôi dưỡng một không gian sống khỏe mạnh, an toàn và hạnh phúc.
Trân trọng!
TỔNG BIÊN TẬP Anh
Bùi Tuấn Anh

TỔNG BIÊN TẬP
Bùi Tuấn Anh
PHÓ TỔNG BIÊN TẬP
Nguyễn Kim Thi
BIÊN TẬP & THIẾT KẾ
Phòng Phát triển Cộng đồng
HỘI ĐỒNG BIÊN TẬP
Lê Tiến Trung
Nguyễn Kim Thi
Hà Thị Hạnh Vân
Bùi Mai Thùy Dương
Huỳnh Thị Thúy Thoa







Mốc là một dạng nấm (fungi) có cấu trúc đơn giản, sinh trưởng và phát triển mạnh mẽ trong môi trường có độ ẩm và nhiệt độ phù hợp. Đây là một hiện tượng rất phổ biến trong đời sống hàng ngày, đặc biệt tại các khu vực khí hậu nóng ẩm như Việt
Nam. Tuy nhìn qua có vẻ chỉ gây mất mỹ quan, nhưng mốc tiềm ẩn nhiều nguy cơ gây hại cho sức khỏe và làm hư hỏng vật chất xung quanh.



1.1 Đặc điểm chung của mốc
» Hình thái:
Mốc thường xuất hiện dưới dạng các
đốm, mảng nhỏ li ti hoặc lớp phủ bông
mịn trên bề mặt vật thể. Màu sắc thay
đổi tùy loại: xanh lá, xanh đen, trắng, vàng, cam… Một số loại mốc phát triển
lan nhanh tạo thành từng mảng lớn,
thậm chí ăn sâu vào cấu trúc vật liệu
như gỗ, vải, giấy.
» Cơ chế sinh sản:
Mốc sinh sản thông qua bào tử - những hạt nhỏ li ti có kích thước siêu nhỏ, không thể nhìn thấy bằng mắt thường. Các bào
tử này phát tán trong không khí và khi
gặp điều kiện thuận lợi (ẩm, tối, ít thông gió), chúng nhanh chóng nảy mầm và phát triển thành mảng mốc mới.
» Tốc độ phát triển:
Chỉ trong vòng 24 - 48 giờ, mốc có thể
bắt đầu hình thành và lan rộng trên bề
mặt vật liệu, đặc biệt là thực phẩm, tường ẩm, khu vực nhà bếp hoặc phòng tắm không thông thoáng.

a. Môi trường phát triển thuận lợi cho mốc
Mốc cần ba yếu tố chính để phát triển mạnh mẽ: độ ẩm, nhiệt độ và chất dinh dưỡng.
» Độ ẩm cao: Khi độ ẩm không khí > 60%, đặc biệt là ở những nơi bị thấm nước, rò rỉ, ngưng tụ hơi nước, mốc dễ dàng phát triển. Nhà cửa ẩm thấp, không phơi nắng hoặc phòng kín ít thông gió là điều kiện lý tưởng cho mốc sinh sôi.
» Nhiệt độ ấm áp: Mốc phát triển mạnh trong khoảng 20oC - 30oC, trùng với nhiệt độ sinh hoạt thường ngày của con người, khiến việc loại bỏ chúng trở nên khó khăn.
» Chất dinh dưỡng: Mốc có thể phát triển trên hầu hết các vật liệu hữu cơ như gỗ, giấy, vải, da, thực phẩm, thậm chí bụi bẩn và dầu mỡ tồn đọng trên các bề mặt.

b. Các bề mặt và vị trí dễ bị mốc tấn công
» Tường, trần nhà: Đặc biệt ở các góc nhà, khu vực có ống nước, dễ bị thấm hoặc ngưng tụ hơi nước.
» Đồ nội thất: Ghế sofa, tủ gỗ, giày dép, quần áo cất lâu ngày trong tủ kín.
» Phòng tắm, nhà bếp: Khu vực ẩm ướt, ít ánh sáng mặt trời.
» Thực phẩm: Bánh mì, hoa quả, cơm nguội, đồ khô bảo quản kém.

Hiểu để xử lý đúng cách

Trong cuộc sống hàng ngày, chúng ta thường dùng từ Mốc để chỉ hiện tượng các đốm nấm xuất hiện trên bề mặt vật dụng hoặc thực phẩm. Tuy nhiên, khái niệm chia thành 2 phần là Mốc (Mold) và Mốc bề mặt (Mildew). Hai khái niệm này không hoàn toàn giống nhau, việc phân biệt đúng sẽ giúp lựa chọn biện pháp xử lý phù hợp và giảm thiểu tác hại đến sức khỏe cũng như tài sản.
a. Định nghĩa cơ bản
» Mốc (Mold): Là tập hợp của nhiều loại nấm sợi đa bào, phát triển thành từng cụm hoặc mảng lớn. Mốc có khả năng ăn sâu vào vật liệu và lây lan nhanh chóng nếu môi trường thuận lợi.
» Mốc bề mặt (Mildew): Là một dạng nấm mốc bề mặt, thường là một số loài mốc yếu hơn hoặc giai đoạn đầu của quá trình phát triển nấm.
Mốc bề mặt (Mildew) thường chỉ bám trên lớp ngoài cùng, ít ăn sâu và dễ vệ sinh hơn.



b. So sánh mốc và mốc bề mặt
Đặc điểm
Màu sắc Mốc (Mold) Mốc bề mặt (Mildew)
Màu sắc Xanh lá, xanh đen, đen, vàng, cam
Trắng xám, đôi khi hơi vàng nhạt
Hình thái
Mức độ ăn sâu
Mảng dày, nổi lên, bề mặt xù xì hoặc lông tơ, có thể ăn sâu vào vật liệu
Cao - lan rộng nhanh, phá hủy cấu trúc gỗ, vải, tường, thức ăn
Tốc độ lây lan Nhanh, có thể bùng phát trong 24-48 giờ nếu độ ẩm cao
Nguy cơ sức khỏe
Có thể sinh độc tố nấm (mycotoxin), gây bệnh hô hấp, dị ứng, tổn thương nội tạng
Lớp mỏng, phẳng, dễ lau chùi, thường loang lổ như bụi phấn
Thấp - chủ yếu trên bề mặt, dễ loại bỏ
Chậm hơn, thường hình thành ở giai đoạn đầu của sự ẩm ướt
Thường chỉ gây kích ứng nhẹ, dị ứng ngoài da, khó chịu khi hít phải
c. Môi trường hình thành –
Cách nhận biết nhanh bằng mắt thường và mùi
Sự xuất hiện của nấm mốc
và Mốc bề mặt thường liên
quan chặt chẽ đến các
yếu tố như độ ẩm, nhiệt độ,
lưu thông không khí và loại
vật liệu. Khi môi trường sống
duy trì tình trạng ẩm ướt
trong thời gian dài, thiếu
ánh sáng và thông gió, bào
tử nấm sẽ dễ dàng sinh sôi
và bám vào bề mặt các
vật dụng. Tuy nhiên, từng
loại nấm lại có xu hướng
hình thành trong điều kiện
và vị trí khác nhau.







Mốc thường xuất hiện ở những nơi có độ ẩm cao kết hợp với sự tồn tại của chất hữu cơ, tạo điều kiện cho bào tử phát triển và lan rộng sâu vào vật liệu. Không gian kín, ít gió và thiếu ánh sáng mặt trời là môi trường lý tưởng để mốc hình thành.
Một số môi trường phổ biến dễ bị mốc:
» Gỗ, giấy, vải hoặc thảm trải sàn: Những vật liệu này dễ hút ẩm, giữ nước lâu, là “thức ăn” tốt cho nấm mốc.
» Thực phẩm để lâu hoặc bảo quản sai cách: Đặc biệt là bánh mì, trái cây, rau củ, đồ khô bị ẩm.
» Khu vực nhà tắm, bếp, kho chứa đồ: Thường xuyên có hơi nước, độ ẩm cao, ít ánh sáng và thông gió kém.
» Tường và trần nhà cũ bị thấm nước: Khi không được sửa chữa kịp thời, mốc sẽ ăn sâu, gây ố màu và mùi khó chịu.


Cách nhận biết nhanh:
Mốc thường để lại dấu hiệu rõ rệt cả về mùi và hình ảnh, đặc biệt khi tình trạng đã kéo dài hoặc ở khu vực không được vệ sinh thường xuyên.
» Mùi đặc trưng: Khá hăng, nồng và gắt, gây cảm giác ngột ngạt, khó chịu, đôi khi khiến người hít phải cảm thấy tức ngực hoặc nghẹt thở trong không gian kín.
Mùi mốc thường bám dai dẳng
trên đồ vật, quần áo và rất khó loại bỏ chỉ bằng việc thông gió hay xịt khử mùi thông thường.
» Dấu hiệu bằng mắt thường: Mốc
hình thành các mảng sần sùi, lan rộng, bề mặt có thể xuất hiện
các sợi nấm mịn hoặc lớp phủ
dày, màu sắc đa dạng như xanh
lá, đen, xám, nâu hoặc cam tùy
loại nấm. Thường thấy trên tường
ẩm, gỗ mục, giấy, thực phẩm để
lâu ngày. Khi đã xuất hiện mảng
mốc dày, việc loại bỏ hoàn toàn
cần sự can thiệp bằng hóa chất hoặc xử lý nguồn ẩm gốc.






Mốc bề mặt hình thành trên bề mặt nhẵn, phẳng, dễ bám nước, chủ yếu trong các không gian ẩm ướt nhưng chưa đạt mức độ
nặng như mốc. Khác với mốc, mốc bề mặt thường phát triển trên
lớp ngoài cùng của bề mặt, ít khi ăn sâu vào vật liệu, nên
Những nơi thường uất hiện mốc bề mặt:
» Bề mặt tường sơn hoặc gạch men: Khi bị đọng nước hoặc không lau khô sau khi tắm rửa, lau nhà.
» Quần áo, rèm, túi xách bằng vải hoặc da: Nếu để trong tủ kín, ẩm, lâu không phơi nắng dễ phát sinh các đốm mốc bề mặt trắng xám.
» Cửa kính, khung nhôm, đồ nội thất phủ sơn bóng: Đặc biệt khi hơi nước ngưng tụ nhiều mà không được vệ sinh thường xuyên.
Cách nhận biết nhanh:
» Mốc bề mặt dễ nhận biết hơn và thường được phát hiện ở giai đoạn sớm hơn mốc vì dấu hiệu nhẹ, mùi không quá nặng, ít khi gây cảm giác ngột ngạt nghiêm trọng.
» Mùi đặc trưng: Nhẹ hơn nhiều so với mốc, thường tương tự mùi ẩm ướt, mùi vải chưa khô hẳn. Mùi này có thể biến mất khi làm khô không gian hoặc giặt sạch vật dụng bị ảnh hưởng.
» Dấu hiệu bằng mắt thường: Mốc bề mặt chỉ để lại lớp bụi mỏng hoặc các chấm nhỏ màu trắng, xám nhạt hoặc hơi vàng, thường tập trung trên bề mặt phẳng, nhẵn bóng như tường sơn, gạch men, vải, da. Khi lau bằng khăn khô hoặc dung dịch vệ sinh, mốc bề mặt thường dễ bị xóa sạch hơn so với mốc ăn sâu vào vật liệu.





Việc hiểu rõ đặc điểm
môi trường hình thành
của từng loại nấm và khả
năng nhận biết chúng
qua mùi và hình dạng là
yếu tố quan trọng giúp
chúng ta chủ động phòng
tránh và xử lý kịp thời. Khi
nắm bắt được những điều
kiện thuận lợi để mốc và mốc
bề mặt phát triển, như độ ẩm
cao, thông gió kém hay bề mặt bị thấm nước, chúng ta có thể thực hiện
các biện pháp phòng ngừa như giảm độ
ẩm trong nhà, tăng cường lưu thông không
khí, phơi khô quần áo và xử lý ngay các
khu vực bị ẩm ướt. Đồng thời, việc quan
sát và nhận biết mùi đặc trưng của từng
loại nấm sẽ giúp phát hiện sớm tình trạng
nhiễm mốc, từ đó kịp thời loại bỏ và ngăn
chặn sự lây lan, bảo vệ chất lượng không
khí và sức khỏe của các thành viên trong
gia đình.


Khía cạnh
Ảnh hưởng
d. Ảnh hưởng lâu dài nếu không ử lý
Mốc (Mold)
đến vật dụng, bề mặt Ăn sâu vào vật liệu hữu cơ như: gỗ, giấy, vải; gây mục nát, bong tróc, đổi màu, làm giảm độ bền và tuổi thọ của đồ vật.
Khó loại bỏ hoàn toàn nếu không xử lý triệt để.
Có thể sản sinh độc tố nấm (mycotoxin) gây tổn thương
Ảnh hưởng
đến sức khỏe
Tốc độ lan rộng
nghiêm trọng cho hệ hô hấp, tăng nguy cơ nhiễm trùng phổi, dị ứng mãn tính và các bệnh kéo dài khó điều trị.
Lan nhanh, bám sâu vào
vật liệu và phát tán mạnh qua
bào tử trong không khí, khó kiểm soát nếu không xử lý nguồn ẩm.
Mốc bề mặt (Mildew)
Chủ yếu gây ố màu, mùi hôi và loang lổ trên bề mặt phẳng (tường sơn, gạch men, vải, da). Ít phá hủy cấu trúc nhưng lâu ngày làm bề mặt xuống cấp và tạo điều kiện để mốc mạnh hơn phát triển.
Thường chỉ gây kích ứng nhẹ như hắt hơi, cay mắt, ngứa mũi.
Nếu để lâu, mốc bề mặt sẽ lan rộng và có thể biến thành mốc nguy hiểm hơn, gây tác hại sức khỏe tương tự.
Lan chậm hơn, chỉ phát triển trên bề mặt, dễ làm sạch nhưng dễ tái phát trong môi trường ẩm.
Khía cạnh Mốc (Mold)

Khả năng
kháng chất tẩy rửa
Mùi và tác
động đến
không khí
Bám chắc, cần dung dịch tẩy rửa
mạnh hoặc biện pháp cơ học (cạo, thay vật liệu). Nhiều trường hợp cần xử lý chuyên nghiệp.
Mốc bề mặt (Mildew)
Dễ lau sạch bằng dung dịch diệt nấm thông thường hoặc nước xà phòng, ít khi cần biện pháp đặc biệt.

Khả năng
tái phát
Nguy cơ gây dị ứng lâu dài
Mùi hăng, nồng, gây khó thở, làm giảm đáng kể chất lượng
không khí trong nhà và gây cảm giác ngột ngạt.
Rất cao nếu môi trường ẩm
không được xử lý tận gốc.
Bào tử có thể tồn tại trong
không khí và bám trên bề mặt lâu dài.
Dễ gây tình trạng mẫn cảm nghiêm trọng, hen suyễn hoặc viêm xoang mãn tính khi tiếp xúc lâu dài.
Mùi nhẹ hơn, tương tự mùi ẩm thấp, gây khó chịu nhưng ít gây nghẹt thở hơn so với mốc.
Cũng dễ tái phát nhưng chỉ khi điều kiện ẩm kéo dài, có thể phòng ngừa bằng vệ sinh và thông gió định kỳ.
Tác động nhẹ hơn nhưng tiếp xúc thường xuyên vẫn có thể gây kích ứng da, mắt và đường hô hấp.


1.3 Tác động của nấm mốc đến sức khỏe con người
Nấm mốc là một trong những yếu tố gây ô nhiễm sinh học phổ biến nhất trong không gian sống và làm việc của con người. Bào tử nấm mốc có thể tồn tại dai dẳng trong không khí, bám lên các bề mặt vật dụng, quần áo, giường nệm và dễ dàng xâm nhập vào cơ thể thông qua đường hô hấp, tiếp xúc qua da hoặc thậm chí qua đường tiêu hóa nếu thực phẩm đã bị nhiễm nấm. Khi môi trường sinh hoạt có sự hiện diện lâu dài của nấm mốc, sức khỏe con người sẽ bị ảnh hưởng một cách âm thầm nhưng liên tục, gây ra nhiều hệ lụy từ nhẹ đến nghiêm trọng. Mức độ tác động phụ thuộc vào loại nấm mốc, mật độ bào tử trong không khí, thời gian tiếp xúc và thể trạng của từng cá nhân.






a. Các phản ứng dị ứng và kích ứng
Một trong những ảnh hưởng đầu tiên và dễ nhận thấy nhất của nấm
mốc là các phản ứng dị ứng và kích ứng ở những người nhạy cảm. Khi
hít phải bào tử nấm, hệ miễn dịch của cơ thể sẽ coi đây là tác nhân
lạ và phản ứng để chống lại, dẫn đến những biểu hiện khó chịu như
hắt hơi liên tục, chảy nước mũi, ngứa mắt, đỏ mắt hoặc nổi mề đay
trên da. Đối với người bị hen suyễn hoặc có cơ địa dị ứng mạnh, việc tiếp xúc với nấm mốc trong thời gian ngắn cũng đủ để gây ra cơn khó thở, tức ngực, co thắt phế quản, thậm chí có thể phải nhập viện nếu không được xử lý kịp thời. Nếu tình trạng tiếp xúc xảy ra thường xuyên, các triệu chứng này có thể trở thành mãn tính, khiến cơ thể luôn trong trạng thái mệt mỏi, suy giảm khả năng tập trung và ảnh hưởng lớn đến chất lượng cuộc sống.


b. Ảnh hưởng đến hệ hô hấp
Nấm mốc là nguyên nhân gây ra nhiều bệnh lý đường hô hấp, nhất là khi tồn tại lâu trong môi trường sinh hoạt
kín, thiếu thông gió. Bào tử nấm có kích thước rất nhỏ, dễ dàng xâm nhập sâu vào phổi, bám vào niêm mạc
đường thở và gây ra các vấn đề như viêm mũi, nghẹt mũi kéo dài, đau xoang hoặc viêm xoang mãn tính. Ở những
người có hệ miễn dịch yếu hoặc bệnh nền về hô hấp, nấm mốc có thể dẫn đến các bệnh nghiêm trọng hơn như viêm phế quản kéo dài, viêm phổi hoặc nhiễm nấm phổi, gây tổn thương mô phổi và giảm dung tích phổi theo thời gian. Không khí chứa nhiều bào tử nấm còn làm tăng nguy cơ bùng phát bệnh hen suyễn, khiến người bệnh thường xuyên lên cơn khó thở, phải dùng thuốc hỗ trợ và gặp nhiều hạn chế trong sinh hoạt hàng ngày.



c. Độc tố nấm và các hậu quả nghiêm trọng hơn
Không chỉ gây dị ứng và bệnh đường hô hấp, một số loại nấm mốc còn sản sinh ra độc tố nguy hiểm gọi là mycotoxin. Đây là những hợp chất có khả năng gây tổn thương trực tiếp đến các cơ quan nội tạng như gan, thận và hệ thần kinh khi con người tiếp xúc lâu dài qua việc hít thở hoặc ăn phải thực phẩm nhiễm nấm. Một trong những loại
độc tố nguy hiểm nhất là aflatoxin - được
Tổ chức Y tế Thế giới (WHO) xếp vào nhóm chất gây ung thư mạnh. Aflatoxin thường xuất hiện trong các loại ngũ cốc, đậu phộng hoặc thực phẩm bảo quản kém, khi bị nhiễm nấm mốc.
Ngoài nguy cơ ung thư gan, các độc tố nấm còn có thể làm suy giảm hệ miễn dịch, khiến cơ thể dễ bị nhiễm trùng khác, kéo dài thời gian hồi phục bệnh, gây mệt mỏi kéo dài, đau đầu, chóng mặt và suy nhược toàn thân. Trong một số trường hợp nghiêm trọng, nhiễm độc nấm mốc có thể gây tổn thương thần kinh, ảnh hưởng đến trí nhớ, khả năng nhận thức và làm suy giảm chất lượng cuộc sống lâu dài.
d. Đối tượng dễ bị tổn thương
Không phải tất cả mọi người đều phản
ứng với nấm mốc ở mức độ giống nhau.
Trẻ sơ sinh và trẻ nhỏ là nhóm dễ bị tổn thương nhất vì hệ miễn dịch chưa hoàn thiện, đường thở nhỏ và nhạy cảm. Khi tiếp xúc với môi trường ẩm mốc, trẻ dễ bị viêm đường hô hấp dưới, viêm phổi hoặc các phản ứng dị ứng mạnh.

Người cao tuổi cũng là nhóm có nguy cơ cao do sức đề kháng suy giảm theo thời gian, khả năng lọc và tự bảo vệ đường hô hấp yếu hơn so với người trẻ. Ngoài ra, những người có hệ miễn dịch suy yếu như bệnh nhân ung thư, HIV/AIDS, hoặc người đang dùng thuốc ức chế miễn dịch, corticosteroid dễ bị nhiễm nấm nghiêm trọng, có thể lan vào máu, gây nhiễm trùng toàn thân và đe dọa tính mạng. Đối với người có cơ địa dị ứng hoặc bệnh nền như hen suyễn, viêm xoang mãn tính, viêm phế quản, sự hiện diện của nấm mốc



Nấm mốc không chỉ xuất hiện trong những thời điểm thời tiết ẩm ướt mà có thể phát triển quanh năm nếu điều kiện thuận lợi, đặc biệt là khi độ ẩm trong nhà vượt quá mức an toàn. Để bảo vệ không gian sống và hạn chế nguy cơ mốc quay trở lại sau khi đã xử lý, cần áp dụng những biện pháp phòng ngừa và kiểm soát độ ẩm một cách lâu dài và bền vững.




2.1 Du trì độ ẩm trong phạm vi an toàn
Mức độ ẩm lý tưởng trong nhà thường dao động từ 30-50%. Khi duy trì được mức này, sự phát triển của nấm mốc sẽ bị hạn chế đáng kể.
» Sử dụng máy hút ẩm hoặc điều hòa không khí có chức năng hút ẩm để giảm lượng hơi nước trong không khí, đặc biệt trong mùa mưa hoặc ở các khu vực khí hậu nhiệt đới ẩm.
» Thông gió thường xuyên bằng cách mở cửa sổ, dùng quạt thông gió trong bếp và phòng tắm để tránh hơi nước tích tụ lâu.
» Đặt các chất hút ẩm tự nhiên như than hoạt tính, gel silica hoặc muối hạt ở những góc khuất, tủ quần áo, nhà kho nhằm ngăn ngừa sự ẩm ướt kéo dài



2.2 Sửa chữa và ử lý nguồn ẩm kịp thời
Nguồn nước rò rỉ dù nhỏ đến đâu cũng có thể tạo môi trường lý tưởng cho nấm mốc sinh sôi.
» Khắc phục các điểm rò rỉ nước từ ống dẫn, bồn rửa, máy giặt hoặc mái nhà ngay khi phát hiện để ngăn nước thấm vào tường và sàn nhà.
» Kiểm tra định kỳ hệ thống thoát nước, đặc biệt sau mưa bão hoặc khi nhà có hiện tượng ẩm bất thường.
» Khi xảy ra sự cố ngập nước hoặc tràn nước trong nhà, cần nhanh chóng làm khô toàn bộ khu vực bằng quạt gió, máy sấy công nghiệp hoặc dịch vụ chuyên dụng
để tránh độ ẩm lưu lại sâu trong vật liệu xây dựng.


2.3 Lựa chọn vật liệu â dựng và nội thất chống ẩm
Việc lựa chọn vật liệu phù hợp ngay từ đầu sẽ giảm thiểu nguy cơ nấm mốc hình thành về lâu dài.
» Sử dụng sơn chống thấm và các lớp phủ bảo vệ đặc biệt cho tường và trần nhà, nhất là ở những khu vực thường xuyên tiếp xúc với nước như phòng tắm, bếp và ban công.
» Ưu tiên các vật liệu có khả năng chống ẩm và chống mốc cho nội thất như gạch men, gỗ đã xử lý chống ẩm, vải sợi tổng hợp ít hút nước.
» Ở những nơi thường xuyên bị ẩm, nên thiết kế hệ thống thoát nước hoặc các khe hở thông gió để giảm tích tụ hơi nước.


2.4 Tha đổi thói quen sinh hoạt để giảm ẩm
Ngoài các giải pháp kỹ thuật, thói quen sinh hoạt hàng ngày cũng đóng vai trò quan trọng trong việc kiểm soát độ ẩm và ngăn ngừa nấm mốc.
» Không phơi quần áo ướt trong không gian kín, đặc biệt là phòng ngủ hoặc phòng khách, vì hơi nước từ quần áo sẽ làm tăng độ ẩm không khí nhanh chóng.
» Vệ sinh máy giặt và khu vực giặt giũ định kỳ để tránh tích tụ cặn bẩn và ẩm mốc, từ đó hạn chế lây lan sang quần áo.
» Sau khi tắm hoặc nấu ăn, nên mở quạt thông gió hoặc cửa sổ để hơi nước thoát ra ngoài thay vì ngưng tụ trên tường và trần nhà.
» Tránh để các vật dụng ẩm lâu ngày trong góc tối, hãy phơi khô hoặc lau khô trước khi cất giữ.


Việc phòng ngừa ẩm mốc đòi hỏi sự kết hợp giữa thiết kế không gian hợp lý, bảo dưỡng thường xuyên và các thói quen sinh hoạt khoa học. Kiểm soát độ ẩm là yếu tố then chốt để hạn chế sự phát triển của nấm mốc trong nhà. Một ngôi nhà thông thoáng, khô ráo và sạch sẽ sẽ gần như không tạo điều kiện cho mốc hình thành.
Bước đầu tiên là giữ độ ẩm trong nhà ở mức lý tưởng từ 30% đến 50%. Có thể sử dụng máy hút ẩm, điều hòa hoặc các thiết bị đo độ ẩm để kiểm soát và theo dõi thường xuyên. Các không gian như phòng tắm, bếp và tầng hầm cần có hệ thống thông gió hoặc quạt hút khí để tránh tình trạng ẩm ướt kéo dài. Cửa sổ và cửa chính nên được mở thường xuyên để đón gió và ánh sáng mặt trời, giúp làm khô tự nhiên các bề mặt dễ bị mốc.


Một trong những nguyên nhân chính gây mốc là sự rò rỉ hoặc thấm nước kéo dài. Vì vậy, cần kiểm tra định kỳ mái nhà, tường, hệ thống ống nước và các khe hở quanh cửa sổ. Bất kỳ vết nứt hoặc rò rỉ nào cũng nên được sửa chữa ngay lập tức. Bên cạnh đó, sơn chống thấm và các vật liệu xây dựng chống ẩm nên được sử dụng để bảo vệ bề mặt tường và sàn nhà, đặc biệt ở các khu vực tiếp xúc thường xuyên với nước.


Thói quen sinh hoạt cũng đóng
vai trò lớn trong việc phòng
ngừa mốc. Không nên phơi
quần áo trong phòng kín hoặc
để đồ dùng ẩm ướt lâu ngày.
Các vật dụng như khăn tắm, thảm chùi chân, rèm cửa cần
được giặt và phơi khô định
kỳ. Ngoài ra, cần vệ sinh bề
mặt nhà bếp và phòng tắm
mỗi ngày để loại bỏ hơi nước
và cặn bẩn, vốn là môi trường thuận lợi cho nấm mốc.


Một số giải pháp bổ trợ gồm:
» Đặt túi hút ẩm hoặc than hoạt tính trong tủ quần áo và những góc khuất ít thông gió.
» Cách nhiệt các bề mặt dễ bị ngưng tụ hơi nước như cửa kính hoặc ống dẫn lạnh.
» Kiểm tra hệ thống điều hòa, vệ sinh định kỳ bộ lọc để tránh tích tụ độ ẩm và bào tử mốc.



Phòng ngừa và kiểm soát
độ ẩm không chỉ giúp
bảo vệ ngôi nhà khỏi các
vết mốc mất thẩm mỹ mà
còn là cách chăm sóc
sức khỏe thiết thực cho
cả gia đình, ngăn chặn
nguy cơ bệnh hô hấp và
dị ứng do mốc gây ra.


Checklist:
15 bước kiểm tra
và vệ sinh chống mốc
Một lịch trình kiểm tra và vệ sinh
định kỳ là chìa khóa giúp mỗi gia
đình chủ động ngăn ngừa ẩm mốc.
Checklist này không chỉ giúp giữ
môi trường sống sạch sẽ mà còn
đảm bảo phát hiện sớm mọi dấu
hiệu bất thường để xử lý kịp thời.
Checklist này nên được dán ở vị trí
dễ nhìn trong nhà, giúp các thành
viên trong gia đình ghi nhớ và thực
hiện đều đặn, đảm bảo ngôi nhà
luôn khô ráo, sạch sẽ và an toàn
cho sức khỏe.

1 Kiểm tra độ ẩm trong nhà Sử dụng ẩm kế, đảm bảo duy trì trong khoảng 30-50%
2 Quan sát tường, trần, sàn
3 Ngửi mùi không khí
4 Kiểm tra hệ thống nước
5 Kiểm tra mái nhà và tường ngoài
Tìm các đốm màu, vết loang lổ, sơn bong tróc - dấu hiệu sớm của mốc
Phát hiện mùi ẩm, mùi hăng hoặc mùi khó chịu bất thường
tuần
Đảm bảo không có rò rỉ tại ống nước, bồn rửa, máy giặt, điều hòa Hằng tháng
Quan sát dấu hiệu thấm nước hoặc nứt nẻ làm nước xâm nhập
6 Làm sạch bề mặt ẩm dễ sinh mốc Lau tường nhà tắm, nhà bếp, khe cửa bằng dung dịch chống mốc
7 Vệ sinh thảm và rèm Giặt hoặc hút bụi kỹ để loại bỏ bụi và bào tử nấm
8 Giặt và phơi quần áo ẩm ướt ngay Không để đồ ẩm trong máy giặt hoặc giỏ đồ lâu
9 Vệ sinh và kiểm tra máy lạnh, quạt hút
10
11
12
Làm khô đồ vật sau khi tiếp xúc nước
Sử dụng dung dịch giấm hoặc baking soda diệt mốc nhẹ
Thông gió thường xuyên
Làm sạch màng lọc, kiểm tra ống thoát nước để tránh ẩm ứ đọng
3-6 tháng
tuần
giặt
1-2 tháng
Lau khô đồ gỗ, kim loại, mặt bếp, khu vực rửa ngay sau khi dùng Hằng ngày
Lau các góc tường, bề mặt thường
cửa sổ, sử dụng quạt thông gió hoặc máy hút
tuần

Ẩm mốc là một vấn đề có thể được ngăn
chặn và kiểm soát nếu mỗi gia đình chủ động hiểu rõ cơ chế hình thành, nguyên nhân và áp dụng các biện pháp phòng ngừa sớm. Việc duy trì môi trường khô ráo, thông thoáng và vệ sinh định kỳ là nền tảng bảo vệ không gian sống và sức
khỏe của các thành viên trong gia đình. Việc kiểm tra thường xuyên, xử lý ngay khi


phát hiện các dấu hiệu ẩm ướt, và trang bị kiến thức cơ bản về ẩm mốc sẽ giúp
bạn tránh được các chi phí lớn và hậu quả sức khỏe lâu dài. Đây cũng là bước chuẩn bị quan trọng để sẵn sàng cho số tiếp theo, nơi chúng tôi sẽ giới thiệu chi tiết
các phương pháp làm sạch và xử lý ẩm
mốc một cách an toàn và hiệu quả, giúp tổ ấm của bạn luôn sạch sẽ và an toàn.




www.lifebalance.vn
